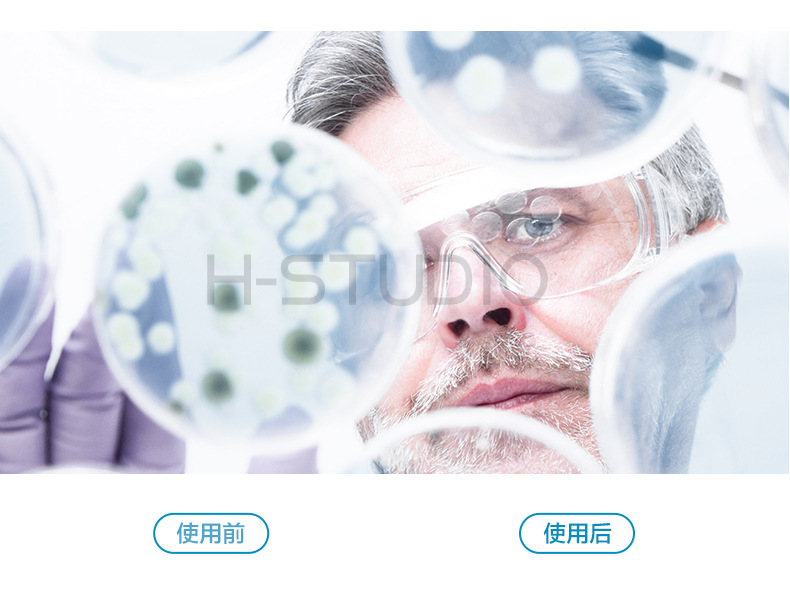
undefined

Маленькое животное домашнее животное применимый биологический дезодорант спрей Черепаха Ящерица кошка собака еж хомяк кролик морская свинка дезодорант
Вес:
0.60 кг
Продано за 30 дней:
0 шт.
Всего продаж:
39748 шт.
Минимальное количество для заказа:
1 шт.
Маленькое животное домашнее животное применимый биологический дезодорант спрей Черепаха Ящерица кошка собака еж хомяк кролик морская свинка дезодорант
от 373.06 ₽ за 1 шт.
-21%
373.06 ₽
Доставка по Китаю включена в цену
Оптом
от 1 шт.
373.06 ₽
Описание

Характеристики
Ли импортировать:
Нет
Эффективность:
Дезодорация
Количество упаковки:
40
Марка:
Другие
Будь источник патента:
Нет
Форма продукта:
Жидкость
Технические характеристики:
Дезодорант флакон (300 мл); Большая бутылка дезодоранта (500 мл); Флакон для дезинфекции и дезодорации (300 мл); Бутылка для дезинфекции и дезодорации (500 мл)
Является ли источник трансграничного экспорта исключительным:
Нет
Категория продукта:
Духи
О продавце
Имя:
Оценка сервиса:
4.5
Оценка логистики:
3.5
Оценка споров и жалоб:
4.0
Оценка предложения:
4.0
Оценка консультации:
3.5
repeatPurchasePercent:
0.6629563594901633
afterSalesExperienceScore:
4.0
qualityRefundWithin30Day:
0.00021465369204350316
Маленькое животное домашнее животное применимый биологический дезодорант спрей Черепаха Ящерица кошка собака еж хомяк кролик морская свинка дезодорант
293.75 ₽
293.75 ₽